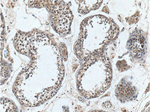
SRD5A1 Antibody in Immunohistochemistry (Paraffin) (IHC (P))

Search
Proteintech
SRD5A1 Polyclonal Antibody
{{$productOrderCtrl.translations['antibody.pdp.commerceCard.promotion.promotions']}}
{{$productOrderCtrl.translations['antibody.pdp.commerceCard.promotion.viewpromo']}}
{{$productOrderCtrl.translations['antibody.pdp.commerceCard.promotion.promocode']}}: {{promo.promoCode}} {{promo.promoTitle}} {{promo.promoDescription}}. {{$productOrderCtrl.translations['antibody.pdp.commerceCard.promotion.learnmore']}}
产品信息
26001-1-AP
种属反应
宿主/亚型
分类
类型
抗原
偶联物
形式
浓度
规格
纯化类型
保存液
内含物
保存条件
运输条件
产品详细信息
Immunogen sequence: MATATGVAE ERLLAALAYL QCAVGCAVFA RNRQTNSVYG RHALPSHRLR VPARAAWVVQ ELPSLALPLY QYASESAPRL RSAPNCILLA MFLVHYGHRC LIYPFLMRGG KPMPLLACTM AIMFCTCNGY LQSRYLSHCA VYADDWVTDP RFLIGFGLWL TGML (1-163 aa encoded by BC007033)
靶标信息
Steroid 5alpha-Reductase is an important enzyme in androgen physiology because it catalyzes the conversion of testosterone into the more potent 5alpha-dihydro-testosterone, which mediates androgen effects on target tissues. The enzyme exists as two isoforms: type 1, which is expressed mainly in the skin; and type 2, which is expressed mainly in the prostate. In cultured human skin cells, 5alpha-Reductase 1 shows heterogeneity of protein, and has different levels of transcriptional and translational expression. 5alpha-Reductase 1 is expressed in all portions of the hair follicle, whereas 5alpha-Reductase 2 is expressed only in mesenchymal portions. In addition, 5alpha-Reductase 1 is mainly expressed in human breast carcinoma and may play a role in the in situ production and actions of the potent androgen 5alpha-dihydrotestosterone, including inhibition of cancer cell proliferation in hormone-dependent human breast carcinoma. The 5alpha-Reductase-3alpha-hydroxysteroid dehydrogenase complex is present in the human brain, suggesting that the complex may be involved in the synthesis of neuroactive steroids or the catabolism of neurotoxic steroids.
仅用于科研。不用于诊断过程。未经明确授权不得转售。
生物信息学
蛋白别名: 3-oxo-5-alpha-steroid 4-dehydrogenase 1; S5AR 1; SR type 1; steroid 5-alpha-reductase (EC 1.3.99.5); Steroid 5-alpha-reductase 1; steroid 5-alpha-reductase type I; steroid-5-alpha-reductase, alpha polypeptide 1 (3-oxo-5 alpha-steroid delta 4-dehydrogenase alpha 1); type 1 5alpha-reductase; unnamed protein product
基因别名: 0610031P22Rik; 4930435F02Rik; S5AR 1; Srd5a-1; SRD5A1
UniProt ID: (Human) P18405, (Mouse) Q68FF9
Entrez Gene ID: (Human) 6715, (Mouse) 78925